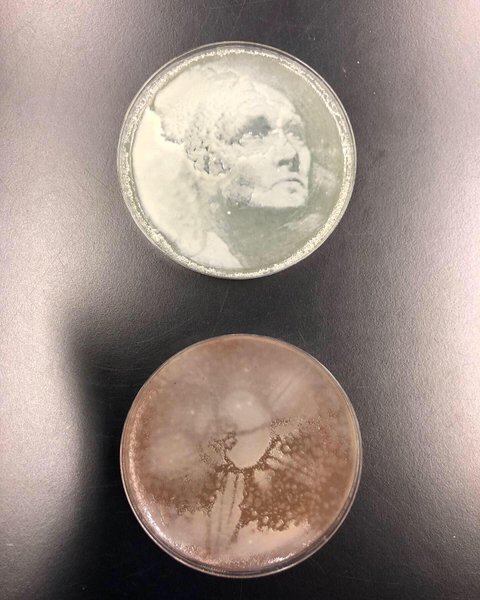
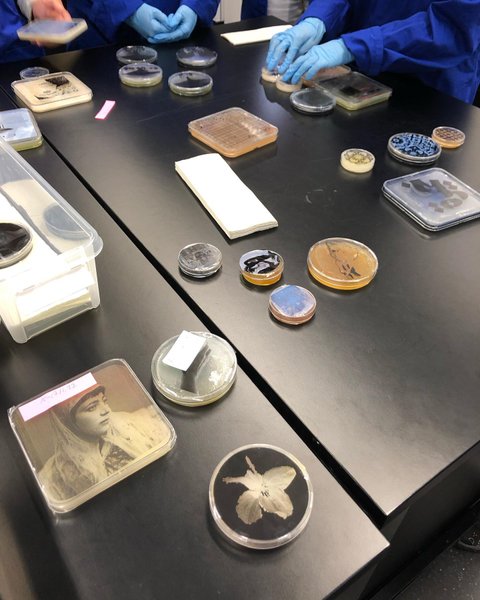
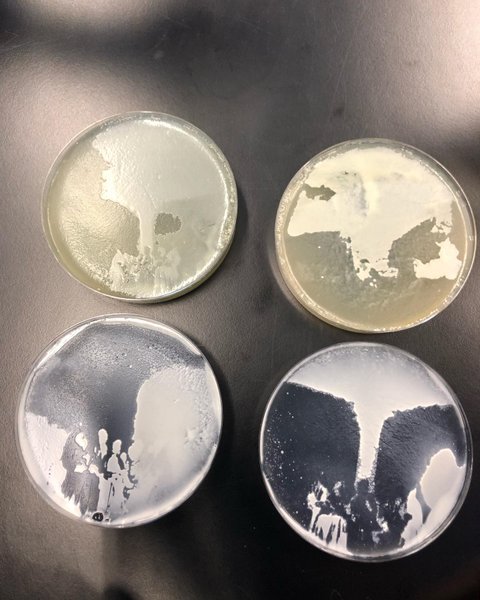
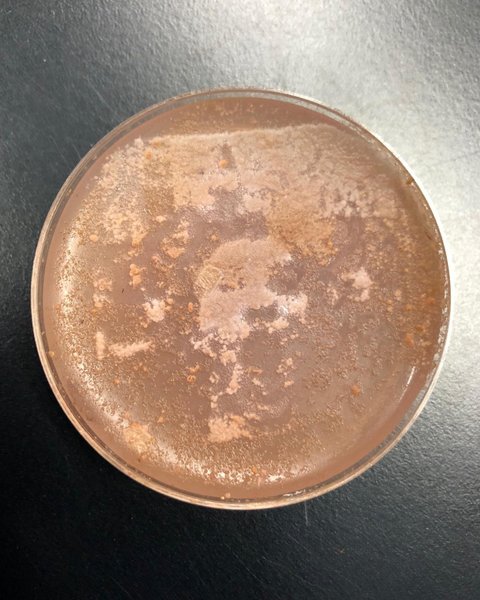

Sublime
An inspiration engine for ideas
Ar′che-type (är′kē̍-tīp), noun [L. archetypum, Gr. ἀρχέτυπον, fr. ἀρχέτυποσ — stamped first and as model ; ἀρχε = ἀρχι + τύποσ stamp, figure, pattern, τύπτειν to strike: cf. F. archétype. See Arch-, pref.]
- The original pattern or model of a work; or the model from which a thing is made or formed.
- (Coinage) The standard weight or coin by which others
Craig Mod • Archetypes Revisited
@abc_aalto 3
We test this idea by building computational models where shape is not gene-encoded, but produced by growth & elasticity #brainTC https://t.co/oXak5tQpKC
Roberto Toro r3rt0@mstdn.social r3rt0.bsky.socialx.com![Thumbnail of [ met-ro-mawr-fuh-sis ] (Sameer Kulavoor, Sandeep Meher)](https://d1l054mla94ehg.cloudfront.net/media/images/thumbnails/curation/b51297d9818e47649276be80282aa7ed/thumbnail.jpg?height=75&dpr=2)
Experimenting with Kangaroo to deform mesh using only the sphere collided component. Differential Growth.
.
.
.
.
.
.
.
.
#grasshopper3d #creativecoding #rhino3d #mesh #kangaroo #mesh #computationaldesign #parametricdesign... See more
instagram.comOur submission to the @ALifeConf Virtual Creatures Competition!
Coming from the paper Evolution and learning in differentiable robots appearing @RoboticsSciSys 2024
With @Kriegmerica, @dmatthews256, and Tyler Hummer @NorthwesternU
Luke Strgarx.comVain evoluutiojutut 🧡 #artificiallife #cyborgs #bioart #yeastogram #yeast #fungus #funghi #hiivagrammi #biofilia #art&science #lab #gallenkallela #tuonela #muotokuva #katse #care
Amazing yeastograms by e.g. @blue.exposures (8.) and @rebekka.y (9.) too 😍🍄❣️
instagram.com